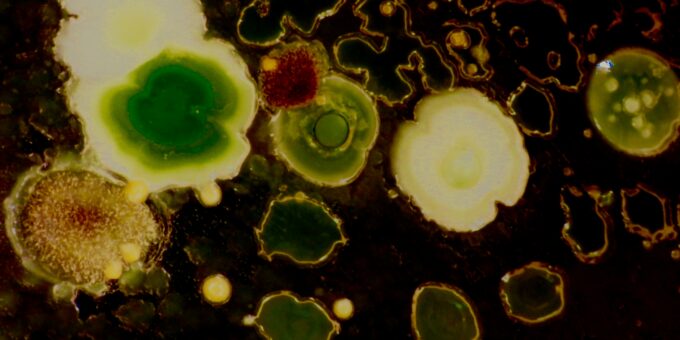

Introduction: The Sleep-Microbe Connection
The human microbiome refers to a complex ecosystem of trillions of microorganisms, including bacteria, viruses, fungi, and protozoa, residing primarily in the gut and on the skin. These microbes play crucial roles in maintaining various bodily functions, significantly influencing human health and well-being. Recent research has begun to unravel the intricate relationship between these microbes and sleep, uncovering how they may affect our sleep patterns and overall sleep quality. Understanding this connection sheds light on the potential impact the microbiome has on our daily lives.
The microbiome’s composition varies from person to person, shaped by factors such as genetics, diet, and environment. This diversity is essential, as different microbes can exert various effects on physiological processes, including the regulation of sleep. Researchers have discovered that certain strains of beneficial bacteria can produce sleep-promoting compounds, such as short-chain fatty acids (SCFAs), which may enhance the quality of sleep. Moreover, the balance of these microbial populations can influence the secretion of neurotransmitters like serotonin and gamma-aminobutyric acid (GABA), which are critical for regulating sleep cycles.
Additionally, disruptions in the gut microbiome, commonly seen in conditions such as dysbiosis, correlate with sleep disturbances and disorders like insomnia. These findings suggest that maintaining a balanced microbiome may be vital for achieving restorative sleep. As we explore the various ways in which specific types of microbes can influence our sleep, it becomes increasingly evident that the sleep-microbe connection is a crucial area of research promising to illuminate strategies for improving sleep health through microbiome modulation.
Microbial Diversity and Sleep Quality
The human microbiome, comprising a vast array of microorganisms residing in various body habitats, plays a significant role in regulating multiple bodily functions, including sleep. Emerging research indicates that the diversity and composition of these microbial communities can profoundly influence sleep quality. A well-balanced microbiome appears to correlate with restorative sleep, while an imbalance may be linked to various sleep disturbances, including insomnia.
Many studies have explored this intricate relationship. For instance, a 2021 study published in the Journal of Clinical Sleep Medicine found that individuals with a richer diversity of gut microbiota reported better sleep quality and fewer sleep disturbances. Specific microbial groups, especially those belonging to the Bacteroidetes and Firmicutes phyla, were noted to be more prevalent in participants who enjoyed restorative sleep. In contrast, an abundance of certain pathogens or a reduced microbial diversity was associated with increased instances of insomnia and disrupted sleep patterns.
Furthermore, specific strains of probiotics, such as Lactobacillus and Bifidobacterium, have shown promise in enhancing sleep quality. Research from Nutrients Journal demonstrated that supplementation with these beneficial bacteria led to notable improvements in sleep duration and deep sleep phases, suggesting a protective role of such microbes against sleep disorders. Conversely, negative impacts on sleep have been observed with higher levels of inflammatory markers associated with dysbiosis, where harmful microbes outnumber beneficial ones.
As the scientific community continues to delve into the connections between sleep and microbial diversity, it becomes evident that nurturing a healthy microbiome through balanced nutrition and lifestyle choices may serve as a practical approach to improve sleep quality. This burgeoning field presents exciting possibilities for developing interventions targeting sleep disturbances through microbiome modulation.
The Role of Gut Health in Sleep Regulation
Recent studies have underscored the significant influence of gut health on sleep regulation, primarily emphasizing the connection established through the gut-brain axis. This intricate system denotes the bi-directional communication between the gastrointestinal system and the central nervous system, highlighting the importance of gut microbiota in modulating various physiological functions, including sleep. Gut microbes are instrumental in producing neurotransmitters and hormones that directly affect sleep cycles; for instance, serotonin, often referred to as the “feel-good” neurotransmitter, plays a pivotal role in regulating melatonin production, which is crucial for controlling sleep-wake patterns.
Additionally, gut microbiota contribute to the synthesis of other compounds known to influence sleep, such as gamma-aminobutyric acid (GABA) and short-chain fatty acids (SCFAs). GABA is a neurotransmitter that promotes relaxation and sleep onset, while SCFAs have been shown to possess neuroprotective properties, potentially impacting sleep quality. This metabolic interplay illustrates the vital role of microbes residing in the gut in maintaining not only digestive health but also optimal sleep functionality.
Moreover, poor gut health can lead to a disruption in these processes, negatively affecting sleep patterns and overall well-being. Dysbiosis, characterized by an imbalance in gut bacteria, has been linked to conditions such as anxiety and depression, both of which can further impair sleep. A disturbed gut microbiome can also result in the overproduction of inflammatory markers, exacerbating sleep disturbances. Consequently, maintaining a healthy gut through balanced nutrition and probiotic supplementation can be crucial for enhancing sleep quality and achieving restorative rest.
Understanding the role of gut health in sleep regulation underscores the importance of nurturing our microbiomes, as doing so may lead to improved sleep patterns and overall health outcomes.
Practical Tips for Promoting a Healthy Microbiome for Better Sleep
Maintaining a healthy microbiome is essential for ensuring quality sleep. One of the primary ways to nourish these beneficial microbes is through diet. Incorporating foods that are rich in probiotics and prebiotics can have a positive impact. Probiotic-rich foods such as yogurt, kefir, sauerkraut, and kimchi introduce beneficial bacteria into your system, while prebiotic foods—such as garlic, onions, asparagus, and bananas—serve as food for these microbes. These dietary changes can help bolster your gut health and, in turn, support better sleep quality.
In addition to dietary interventions, adopting a consistent exercise routine can significantly influence microbiome health and sleep patterns. Regular physical activity can help stimulate the growth of beneficial gut bacteria, which are critical for metabolic and immune functions. Furthermore, exercise has been shown to improve sleep quality by promoting relaxation and reducing stress levels. It is important to aim for at least 150 minutes of moderate aerobic activity per week to reap these benefits.
Hydration also plays a vital role in facilitating a balanced microbiome. Adequate water intake can aid digestion and the overall functioning of gut flora. Aim for at least eight 8-ounce glasses of water daily, adjusting as necessary based on individual activity levels and environmental factors. Additionally, establishing good sleep hygiene practices is key. This entails maintaining a consistent sleep schedule, creating a relaxing bedtime routine, and ensuring that your sleep environment is conducive to rest.
In conclusion, fostering a healthy microbiome through diet, exercise, and proper hydration not only supports overall health but also enhances sleep quality. Implementing these practical tips can lead to improved gut health and a more restorative sleep experience, ultimately benefiting your well-being.